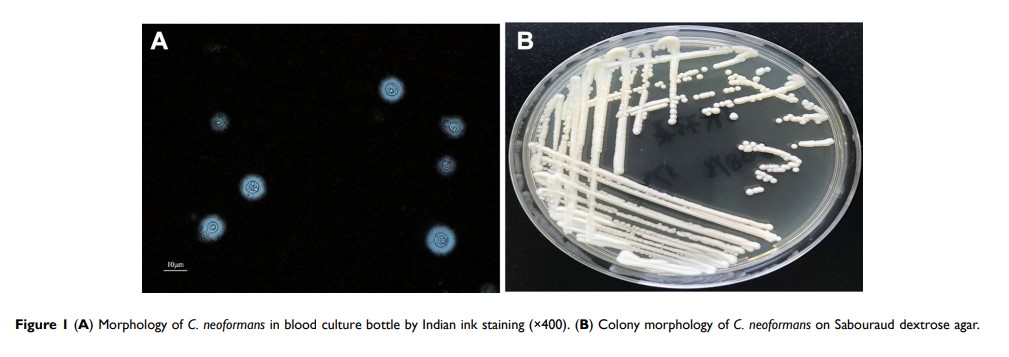

109814
论文已发表
注册即可获取德孚的最新动态
IF 收录期刊
- 3.4 Breast Cancer (Dove Med Press)
- 3.2 Clin Epidemiol
- 2.6 Cancer Manag Res
- 2.9 Infect Drug Resist
- 3.7 Clin Interv Aging
- 5.1 Drug Des Dev Ther
- 3.1 Int J Chronic Obstr
- 6.6 Int J Nanomed
- 2.6 Int J Women's Health
- 2.9 Neuropsych Dis Treat
- 2.8 OncoTargets Ther
- 2.0 Patient Prefer Adher
- 2.2 Ther Clin Risk Manag
- 2.5 J Pain Res
- 3.0 Diabet Metab Synd Ob
- 3.2 Psychol Res Behav Ma
- 3.4 Nat Sci Sleep
- 1.8 Pharmgenomics Pers Med
- 2.0 Risk Manag Healthc Policy
- 4.1 J Inflamm Res
- 2.0 Int J Gen Med
- 3.4 J Hepatocell Carcinoma
- 3.0 J Asthma Allergy
- 2.2 Clin Cosmet Investig Dermatol
- 2.4 J Multidiscip Healthc

-
Original Research
环状 RNA circEXOC6B 通过使海绵化 miR-421 及调节 RUS1 表达来抑制卵巢癌的进展

- 作者:Zhonghai Wang, Wenmin Zhang, Jinchuan Fang, Ping Xie, Miao Miao, Hongwen Yang
- 期刊:OncoTargets and Therapy
-
Original Research
LINC01089 通过调节 miR-27b-3p/HOXA10 轴来阻止结直肠癌细胞的增殖和转移

- 作者:Ming Li, Xufeng Guo
- 期刊:OncoTargets and Therapy
-
Case Report
免疫检查点抑制剂治疗可以完全缓解药物敏感的、有高肿瘤负担的 EGFR/ALK 突变-阴性转移性肺大细胞神经内分泌癌:一份病例报告

- 作者:Xin Zhang, Yanbin Sun, Yuan Miao, Shun Xu
- 期刊:OncoTargets and Therapy
-
Case Report
乳头糜烂性腺瘤病:临床诊断的一个挑战

- 作者:Shuni Ying, Hong Fang, Jianjun Qiao
- 期刊:Clinical, Cosmetic and Investigational Dermatology
-
Case Report
播散性隐球菌病患者的血清隐球菌抗原假阴性侧流免疫测定结果
- 作者:Yuqiao Xu, Wenying Xia, Fang Ni
- 期刊:Infection and Drug Resistance
-
Original Research
锌螯合剂 N,N,N,N′,N′-四(2-吡啶甲基)乙二胺可降低脓肿分枝杆菌对亚胺培南的耐药性

- 作者:Siyuan He, Yuzhen Zou, Mengling Zhan, Qi Guo, Yongjie Zhang, Zhemin Zhang, Bing Li, Shaoyan Zhang, Haiqing Chu
- 期刊:Infection and Drug Resistance